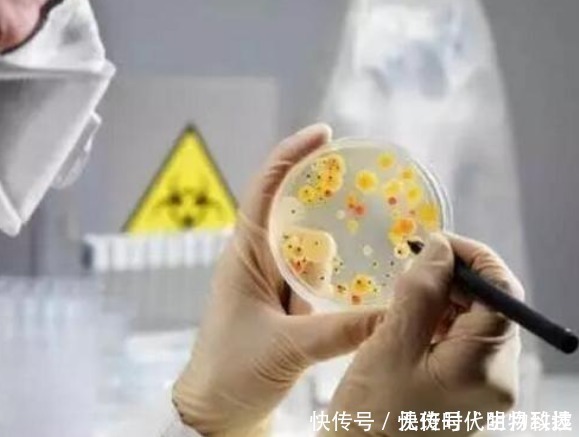
实验室|无斑时代PH450代谢酶科技祛斑,看完才知道值得

实验室|无斑时代PH450代谢酶科技祛斑,看完才知道值得
无斑时代PH450代谢酶科技祛斑,看完才知道值得
不知道大家最近有没有发现,护肤界这几年的国货风是越刮越大,但是对于很多不明真相的吃竹群众来说,也不知道是国货真的崛起,到底还是商家耍的阴谋手段。

文章插图
就像之前很多人口中说的无斑时代,因为有些人根本没有使用过,饱受争议的PH450代谢酶祛斑科技,到底真的有没有那么好用呢?但是作为严谨的无斑时代来说,这无疑是一个小争议,不过无斑时代确实用效果证明了自己。
首先,得先介绍一下关于无斑时代的Ph450代谢酶科技到底是怎么回事。

文章插图
1978年,沃纳·阿尔伯团队经过多年研究,发现了限制性内切酶而获得了该年度的诺贝尔医学和生理学奖。这个酶是科学家研究DNA的最重要的工具,正是因为有了它,遗传工程才终于变成了现实。获奖后阿尔伯博士把目光转向了微生物的进化领域,带领专项小组合成出了第一个“人造生命”,曾经引起国内外媒体争相报道。
【 实验室|无斑时代PH450代谢酶科技祛斑,看完才知道值得】

文章插图
1997年,为推动“细胞生物酶临床化造福人类”联合多国细胞医学领域科学家,以临床应用为目标的科研,在瑞士保罗谢勒国家研究所成立“瑞士PH450国际联合课题组”成为全球皮肤细胞CYP酶技术领域临床应用的顶级科学发烧友平台。
为了更好地将技术应用于生活,无斑时代围绕PH450酶的生活应用,联合全球18个干细胞医学研究实验室对皮肤问题细胞疗法及保养研究,临床应用的细胞治疗史中获得全球的认可项目高达900项。

文章插图
“用科技,打动肌肤”,无斑时代一直以行动践行品牌理念。为了让品质技术得以应用,无斑时代联手瑞典卡罗林医学院、瑞士干细胞银行、哈佛大学生命科学院、瑞士保罗谢勒研究所、英国剑桥分子生物学实验室等18所医学研究实验室将PH450酶的应用进行临床研究,斥巨资打造技术品质底蕴。
PH450酶,由于其PH值与皮肤PH值相似成弱酸性;与PH弱碱性P450不同的是,它可以靶向活跃于肌肤各层次细胞之间;制造肌肤细胞色素及毒素溶解代谢通道。

文章插图
实验室拥有超过16000份植物干细胞样品,构成了最具规模的私人植物样品收藏。产品中的活性成分都提取自然植物。每年会开发3-5个新的植物活性成分和植物提取物,专利性细胞提取研究也在不断的突破创新中。
文章插图
而很多人都搞错了有个点就是色斑的成因,无斑时代很长时间的研究表明,色斑的病因是PH450酶的缺乏,造成的面部色素代谢障碍;而亚健康和光老化只是诱因。祛斑时代,由于把“诱因”理解“病因”;一直对外抵抗“光老化”,对内阻止色素形成和毒素沉积。把正常的人体代谢理解为“病态”,错误的走了几个世纪。“祛斑”一词将成为历史,“排斑”才是正道及未来。
经验总结扩展阅读
- 人体“看脸”时代,为什么总有人“表里不一”?
- 时代好棉做年礼 全棉时代新年棉品温情上线
- 面的人均“油腻”的时代,少不了它
- 时代真珠美学APP把握时代潮流,打造轻奢美妆护肤产品
- 时代瑷偲特护肤讲堂 | 视觉时代,你的年龄和肌龄相符吗?
- Agf中科臻颜胶原魔法——人源三型胶原蛋白,开启功能蛋白美肤时代!
- 品牌欧玛Phyto-C科学实验室配方,精准改善肌肤问题
- 六大六大战略布局轻医美 新新氧揭开新医美时代
- 活动资讯|新时代“新时丽人营——出水‘敷’容”沙龙活动在江苏成功举办
- 人参“空间元炁”终将引领健康护肤新时代
